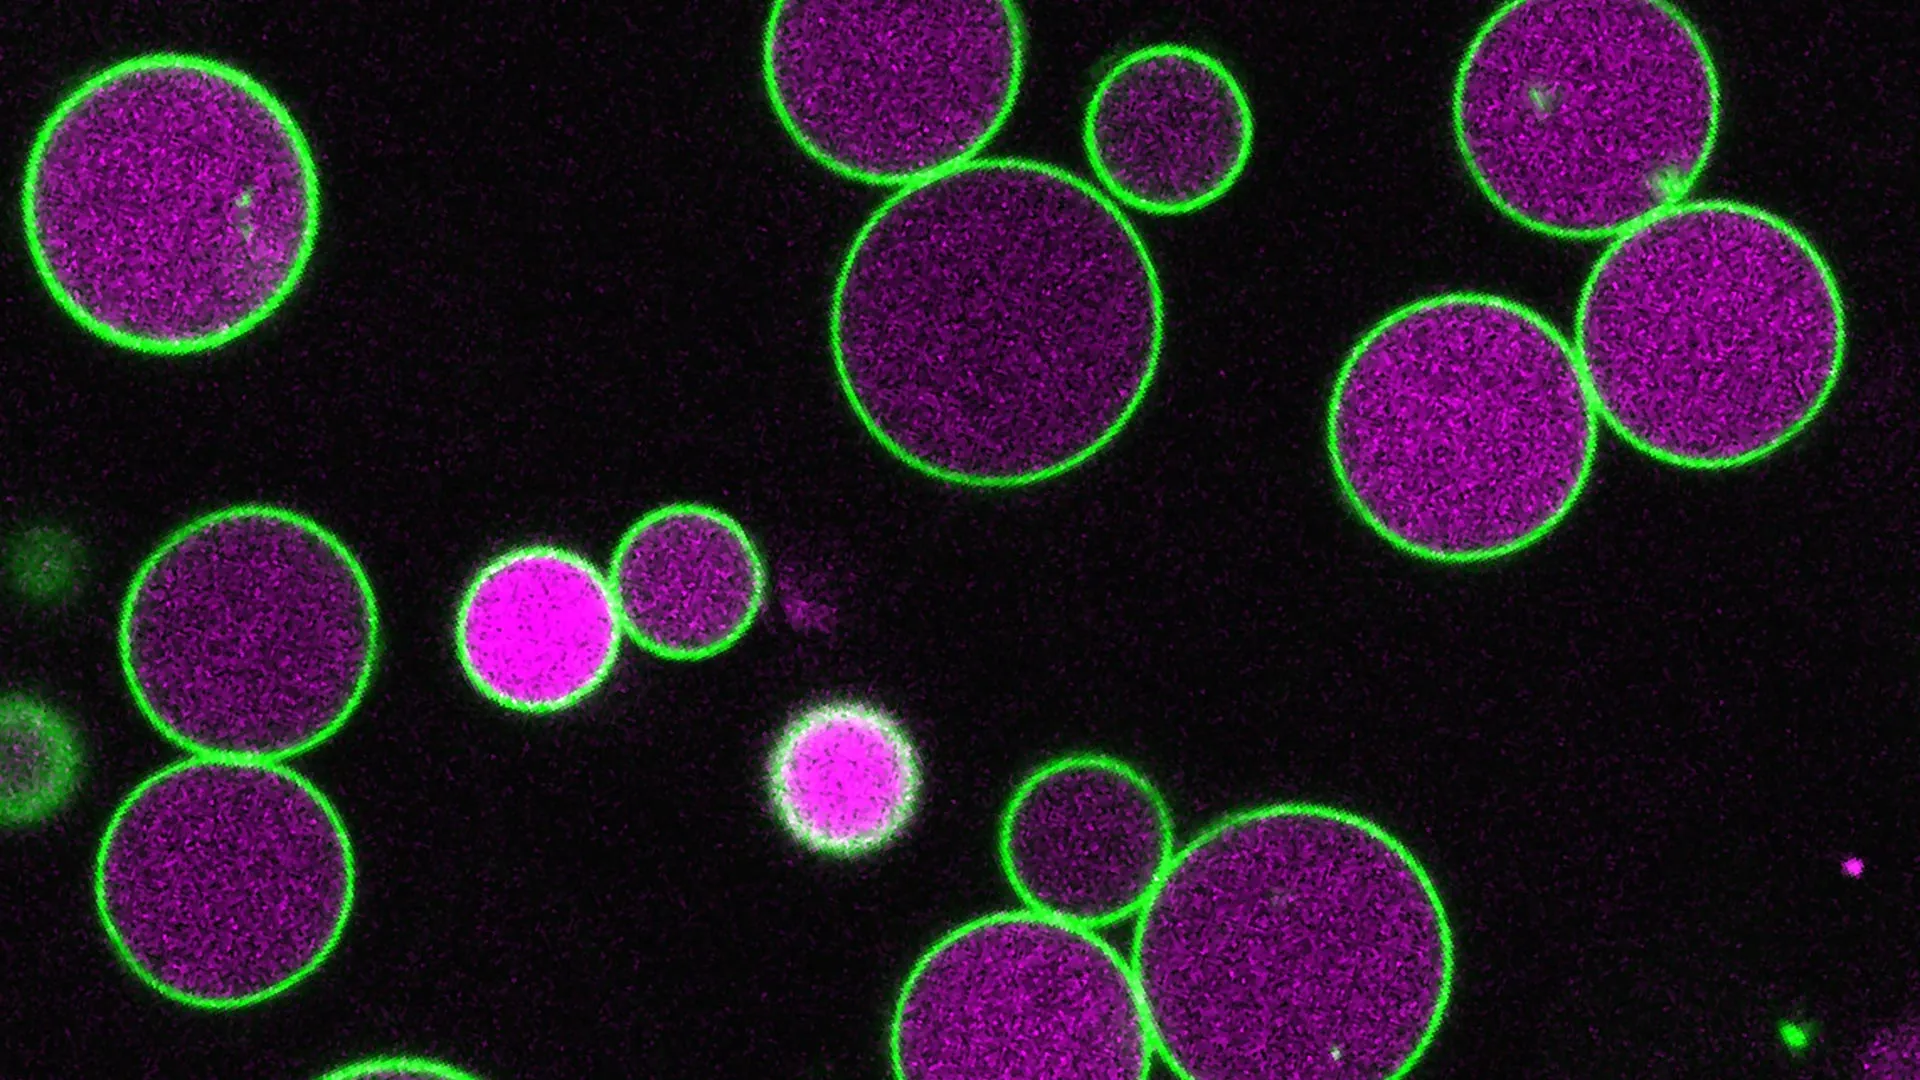

Three hundred million years ago, Earth looked nothing like it does today. The continents were joined together in a massive supercontinent called Pangaea. Near the equator, vast coal-swamp forests stretched across the landscape. Oxygen levels in the atmosphere were much higher than today, and wildfires were frequent.
Life was abundant in every environment. Oceans were filled with fish, while land was home to amphibians, early reptiles, crawling arthropods, and even giant cockroaches. Overhead, the skies belonged to insects, some of which reached astonishing sizes.
Dragonflies With Massive Wingspans
Among these prehistoric insects were mayfly-like species with wingspans of 17 inch (45-cm) and dragonfly-like creatures that reached 27 inch (70-cm). These giant insects, often called “griffinflies,” were first identified from fossil impressions found in fine-grained sedimentary rock in Kansas nearly a century ago.
For decades, scientists believed these enormous insects could only exist because oxygen levels in the atmosphere were about 45% higher than they are today. A new study now challenges that long-standing idea.
The Oxygen Theory Behind Giant Insects
In the 1980s, researchers developed techniques that allowed them to reconstruct the composition of ancient atmospheres. Their results showed that oxygen levels peaked around 300 million years ago.
Building on this discovery, a 1995 study published in Nature linked that oxygen-rich period to the presence of giant insects. Scientists proposed that larger insects required more oxygen, and that higher atmospheric oxygen made their size possible.
This explanation was based on how insects breathe. Instead of lungs, insects rely on a network of air-filled tubes called a tracheal system. These tubes branch throughout the body and end in tiny structures called tracheoles. Oxygen moves through these tracheoles by diffusion, traveling down concentration gradients to reach the flight muscles.
Because diffusion becomes less efficient over longer distances, researchers concluded that modern oxygen levels would not be sufficient to support the energy demands of extremely large flying insects.
New Study Challenges Long-Held Assumptions
A new study published in Nature offers a different perspective. Led by Edward (Ned) Snelling of the University of Pretoria, the research team used high-power electron microscopy to examine how insect body size relates to the number of tracheoles in flight muscle.
Their findings showed that tracheoles typically occupy only about 1% or less of the flight muscle in most insect species. Even when this relationship is applied to the massive griffinflies that lived 300 million years ago, the proportion remains small.
This suggests that insect flight muscles are not limited by oxygen availability. Because tracheoles take up so little space, insects could theoretically increase their number without major structural constraints.
Evidence From Modern Insects
“If atmospheric oxygen really sets a limit on the maximum body size of insects, then there ought to be evidence of compensation at the level of the tracheoles,” said lead author Edward (Ned) Snelling, associate professor, and Faculty of Veterinary Science at the University of Pretoria. “There is some compensation occurring in larger insects, but it is trivial in the grand scheme of things.”
Further supporting this idea, researchers compared insects with vertebrates. In birds and mammals, capillaries in heart muscle occupy about ten times more space than tracheoles do in insect flight muscle.
“By comparison, capillaries in the cardiac muscle of birds and mammals occupy about ten-times the relative space than tracheoles occupy in the flight muscle of insects, so there must be great evolutionary potential to ramp up investment of tracheoles if oxygen transport were really limiting body size,” said professor Roger Seymour of Adelaide University.
The Mystery of Giant Insect Size Remains
Some scientists caution that oxygen might still play a role in limiting insect size, particularly in other parts of the body or earlier stages of oxygen transport. As a result, the idea that oxygen constrains insect size has not been completely ruled out.
However, the new findings clearly show that oxygen diffusion within flight muscle tracheoles is not the limiting factor. This means researchers must explore other explanations for why insects once grew so large.
Possible factors include increased predation from vertebrates or physical limitations of the insect exoskeleton. For now, the true reason behind the rise and disappearance of giant insects remains an open question.